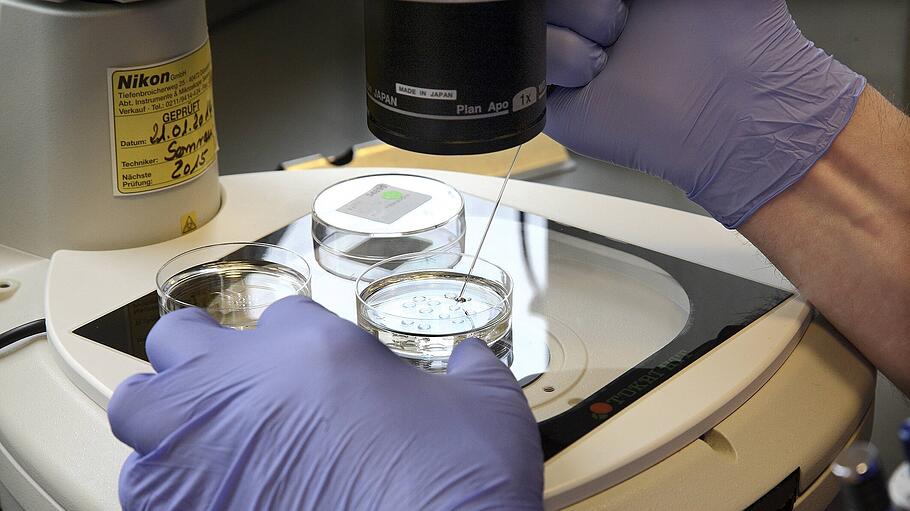

Die Göttinger Medizinethikerin Claudia Wiesemann hat sich für eine bedingte Zulassung der in Deutschland verbotenen Eizellspende ausgesprochen. Dem Berliner „Tagespiegel“ sagte die Direktorin des Instituts für Ethik und Geschichte der Medizin an der Universitätsmedizin Göttingen, man könne die Risiken klein halten und dafür sorgen, dass eine Spende nur erfolge, wenn die Frau aufgeklärt einwillige.
Ampel will Legalisierung prüfen
Bislang verbietet das Embryonenschutzgesetz (ESchG) die Eizellspende. SPD, Bündnis 90/Die Grünen und FDP haben jedoch in ihrem Koalitionsvertrag die Einrichtung einer Kommission vereinbart, die unter anderen die Legalisierung von Eizellspende und Leihmutterschaft prüfen soll.
Wiesemann, die von 2012 bis 2020 Mitglied des Deutschen Ethikrats war, wurde 2021 zum Mitglied der Nationalen Akademie der Wissenschaften Leopoldina gewählt. 2019 hatte die Leopoldina unter dem Titel „Fortpflanzungsmedizin in Deutschland – für eine zeitgemäße Gesetzgebung“ eine Stellungnahme publiziert, in der unter anderem eine Legalisierung der Eizellspende gefordert wird. DT/reh